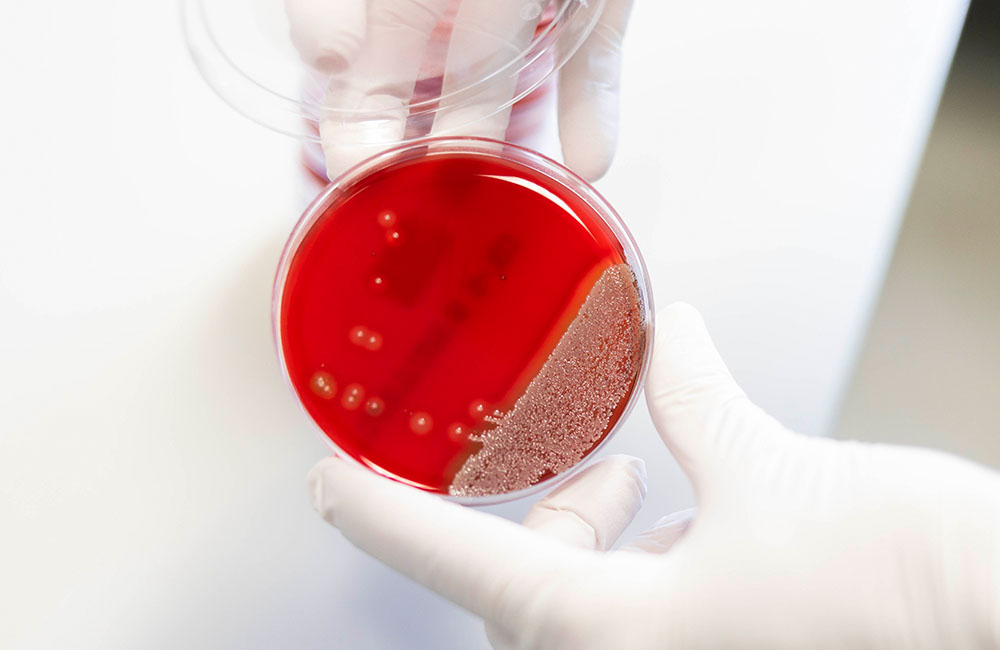
Staphylococcus aureus_Sarah Kossmann

Groundbreaking insights gained in the treatment of bloodstream infections
An international clinical study led by Professor Achim Kaasch, MD, Head of the Institute of Medical Microbiology and Hospital Hygiene at Otto von Guericke University Magdeburg and Professor Harald Seifert, MD, former Deputy Director of the Institute of Medical Microbiology, Immunology and Hygiene at the University Hospital of Cologne, has provided crucial new insights into the treatment of bloodstream infections with the pathogen Staphylococcus aureus (SAB). The research shows that in patients with a low risk of infection complications, an early switch to oral antibiotic therapy is just as effective and safe as continuing conventional intravenous treatment. For patients, this new therapeutic approach enables simpler treatment and faster discharge from hospital. The results of the study, which involved researchers in Magdeburg and Cologne as well as scientists from Heinrich Heine University Düsseldorf and the German Center for Infection Research (DZIF), have been published in the journal The Lancet Infectious Diseases.
The bacterium Staphylococcus aureus is one of the most common pathogens worldwide that can cause severe bloodstream infections - also known as sepsis or blood poisoning.An estimated 30,000 people in Germany alone contract this infection every year, and around 25 percent of those affected die within the first three months. Professor Kaasch explains: "If SAB is not treated adequately, there is a serious risk of the infection spreading to other parts of the body.Even after successful treatment, an infection can often have a negative impact on the patient's recovery process for several months."

Foto: Prof. Dr. med. Achim Kaasch. Fotografin: Sarah Kossmann/Universitätsmedizin
Conventional treatment of SAB involves at least 14 days of intravenous antibiotics administered in hospital.The research group's study focused on the question of whether oral therapy with tablets is just as effective as conventional intravenous treatment in patients with SAH."We found that an early switch to oral antibiotic therapy after 5 to 7 days of intravenous treatment is just as safe and effective as the established standard intravenous therapy," says Kaasch. Nevertheless, according to the microbiologist, a careful assessment of patients for signs and symptoms is necessary in order to clarify whether complications of infection are already present. Only if these have been ruled out can oral conversion therapy be considered.
The results of this groundbreaking study mark a significant advance in the treatment of Staphylococcus aureus bloodstream infections and offer hope for improved care for patients worldwide. "These findings open up the possibility of simplifying treatment and discharging patients more quickly," emphasizes Kaasch.
Foto: Staphylococcus aureus. Fotografin: Sarah Kossmann/Universitätsmedizin
In further studies, the scientists want to investigate various questions relating to the diagnosis and treatment of SAB. "It is now particularly relevant to test a switch to oral antibiotic therapy after initial intravenous treatment, even in patients with complicated Staphylococcus aureus bloodstream infections," explains Professor Seifert from Cologne University Medicine and initiator of the study. "There are no findings on this yet."

Foto: Prof. Dr. med. Harald Seifert, Universitätsklinik Köln
Science Minister Prof. Dr. Armin Willingmann emphasized: "It is no coincidence that this groundbreaking international study was conducted under the leadership of Magdeburg University Hospital. It stands for top-class medical research in many areas, from which numerous patients benefit in addition to science and academic teaching.Microbiology in particular, under the direction of Prof. Kaasch, has made a name for itself both nationally and internationally in recent years. The fact that the research results achieved here attract worldwide attention also strengthens Saxony-Anhalt as a science location as a whole."
The study conducted is a multicenter, controlled clinical non-inferiority trial.It was conducted at 31 sites in Germany, France, the Netherlands and Spain.The aim of such a study is to show that a new treatment method achieves equivalent results to the established treatment.In total, data was collected from over 5,000 patients. The study included 213 participants, 108 of whom were randomly assigned to the oral group and 105 to the intravenous group. It was funded by the German Research Foundation.
Original publication: Efficacy and safety of an early oral switch in low-risk Staphylococcus aureus bloodstream infection (SABATO): an international, open-label, randomised, controlled, non-inferiority trial; The Lancet Infectious Diseases; 18.01.2024; DOI https://doi.org/10.1016/S1473-3099(23)00756-9
Scientific contacts
- Prof. Dr. med. Achim Kaasch, Director at the Institute for Medical Microbiology and Hospital Hygiene at Otto von Guericke University Magdeburg, phone: +49-391-67-13392, achim.kaasch@med.ovgu.de
- Prof. Dr. med. Harald Seifert, Former Deputy Director at the Institute for Medical Microbiology, Immunology and Hygiene at Cologne University Hospital, harald.seifert@uni-koeln.de
